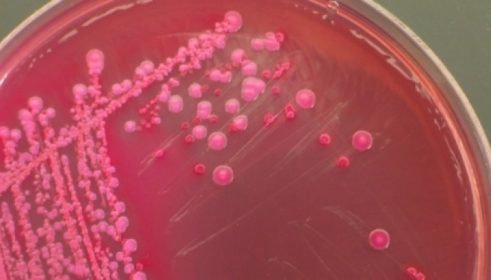
post-image

Căpşunile se presează uşor într-o sită pentru spălat fructe (de preferinţă din material plastic) pusă deasupra unei oale în...
Trebuie sa stii
Author Cristina PetrescuPosted on
Acum poti scoate mai usor petele de pe hainele preferate. Ingredientul banal din bucatarie te ajuta sa scoti pete...
Author Marian IvanPosted on
Denisa Comanescu este campioana mondiala la patinaj artistic pe role in-line si o patinatoare promitatoare pe gheata. Aceasta este...
Author Cristina PetrescuPosted on
Escherechia Coli este o bacterie des intalnita in intestinele oamenilor si al animalelor. Majoritatea bacteriilor care apartin acestui gen sunt...
Author Marian IvanPosted on
Ai bijuterii din argint pe care nu le mai porți pentru că s-au înnegrit sau cele din aur nu...
Author Marian IvanPosted on
După ce a constatat că întâmpină dificultăți în folosirea mâinii drepte, Andreea Marin a ajuns pe mâinile unor specialiști...
Author Marian IvanPosted on
Iulia Albu a afirmat că este pregătită să se căsătorească din nou și a declarat că-și mai dorește copii....
Author Cristina PetrescuPosted on
Inspectorii ANPC au retras de pe piata cuburi de gheata vandute la punga in marile magazine. Cauza: erau facute...
Author Marian IvanPosted on
Sfinții Împărați Constantin și Elena sunt sărbătoriți pe data de 21 mai atât de bisericile ortodoxe, cât și de...
Author Marian IvanPosted on
Fostul Principe Nicolae și soția sa, Alina-Maria Binder, au anunțat locul în care se va desfășura ceremonia religioasă din...